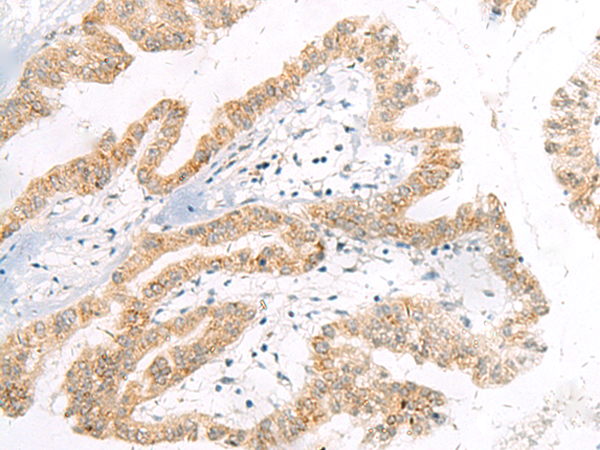

中文名稱: 兔抗MOB2多克隆抗體
英文名稱: Anti-MOB2 rabbit polyclonal antibody
別 名: MOB kinase activator 2; HCCA2
相關(guān)類別: 一抗
儲(chǔ) 存: 冷凍(-20℃)
宿 主: Rabbit
抗 原: MOB2
反應(yīng)種屬: Human, Mouse, Rat
標(biāo) 記 物: Unconjugate
克隆類型: rabbit polyclonal
技術(shù)規(guī)格
|
Background: |
MOB2 (Mps one binder kinase activator-like 2), also known as HCCA2 (Hepatocellular carcinoma-associated gene 2), is a 467 amino acid protein that belongs to the MOB1/phocein family. MOB2 is expressed in lung, spleen, brain, and fetal liver. It is highly expressed in hepatocellular carcinoma. MOB2 is localized in the perinuclear region of the cytoplasm in liver cancer tissues and colocalizes with MAD2L2 in the nucleus of Hela cells. MOB2 is characterized by two N-glycosylation sites, six N-myristolylation sites, two Src homology 3 (SH3), and several phosphorylation motifs which indicate that this protein may play a role in an intracellular signal transduction cascade. MOB2 binds to and regulates the autophosphorylation of the related human serine/threonine kinase 38 (NDR1) and serine/threonine kinase 38L(NDR2). It has been shown that MOB2 plays a critical role in cell cycle regulation. Overexpression of the protein during the G0/G1 phase inhibits cell proliferation causing cell cycle arrest. Stimulates the autophosphorylation and kinase activity of STK38 and STK38L. |
|
Applications: |
ELISA, WB, IHC |
|
Name of antibody: |
MOB2 |
|
Immunogen: |
Synthetic peptide of human MOB2 |
|
Full name: |
MOB kinase activator 2 |
|
Synonyms: |
HCCA2 |
|
SwissProt: |
Q70IA6 |
|
ELISA Recommended dilution: |
5000-10000 |
|
IHC positive control: |
Human liver cancer and Human thyroid cancer |
|
IHC Recommend dilution: |
20-100 |
|
WB Predicted band size: |
27 kDa |
|
WB Positive control: |
Mouse liver tissue and Rat liver tissue lysates |
|
WB Recommended dilution: |
200-1000 |

購物車
幫助
021-54845833/15800441009
